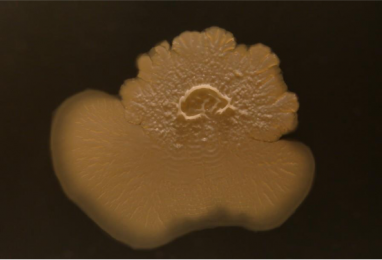

De 23 a 26 de outubro, o Festival Semibreve regressa a Braga com um cartaz diversificado que, mais uma vez, integra na sua programação propostas artísticas criadas por alunos de instituições de Ensino Superior.
No ano em que o festival celebra a sua 15ª edição, a programação inclui duas instalações da autoria de estudantes da Escola das Artes (EA), Isidora Correa e Rafael Maia, ambos estudantes de Doutoramento em Ciência e Tecnologia das Artes.
O festival de música eletrónica e arte digital acontece em diversos locais da cidade de Braga, como o Santuário do Bom Jesus, a Capela Imaculada, o Theatro Circo e o Gnration, onde poderão ser encontradas as instalações da EA.
Micro Ecologias da Mineração e SIFIE: Dark Matter poderão ser visitadas a partir de 23 de outubro.
Artistas: Isidora Correa & Guy
Micro Ecologias da Mineração cruza escultura, vídeo e arte sonora para explorar as implicações ambientais da energia sustentável. A instalação imersiva mostra o crescimento de bactérias extremófilas do Salar de Atacama — organismos que sobrevivem a condições salinas e áridas através da cooperação. Entre as formas de vida mais antigas do planeta, simbolizam resiliência às mudanças ambientais, agora ameaçadas pela extração de lítio. Esculturas de vidro replicam morfologias de crostas salinas e contêm biolixiviação com extremófilos para recuperar lítio de baterias descartadas. Um sistema interativo sonifica mudanças de cor microbiana, traduzindo processos vivos numa ecologia sónica generativa de recirculação mineral.
Esta obra foi desenvolvida no âmbito do Programa de Doutoramento em Ciência e Tecnologia das Artes, na Escola das Artes da Universidade Católica Portuguesa (CITAR), sob a supervisão das Professoras Doutoras Cristina Sá e Patrícia Moreira, com o apoio da Fundação para a Ciência e a Tecnologia (FCT), Portugal.

Fotografia de Francisco Dias
Artista: Rafael Maia
SIFIE: Dark Matter é uma instalação sonora que investiga a nossa relação timbrica com o som e como esta molda a realidade auditiva que escolhemos habitar. Ao extrair as possíveis alterações timbricas de uma voz na matéria negra, é criado um cenário de ambiguidade auditiva ao redor da escultura, provocando o ouvinte a atribuir conscientemente ou inconscientemente uma forma a estes objetos sonoros. Essas respostas cognitivas, revelam os nossos preconceitos auditivos: o que substituímos ou ignoramos para sermos capazes de lidar com o quotidiano incerto. Um ponto de convergência acústica, depois de encontrado, colapsa todas as possibilidades geradas pelos visitantes numa só, revelando o conteúdo inalterado da voz. Ao confrontar-nos com estas duas dimensões, a instalação afirma-se como um ato de resistência a narrativas impostas.
Esta obra foi desenvolvida no âmbito do Programa de Doutoramento em Ciência e Tecnologia das Artes, na Escola das Artes da Universidade Católica Portuguesa, sob a supervisão do professor José Alberto Gomes.
Mais informações sobre o Festival aqui.